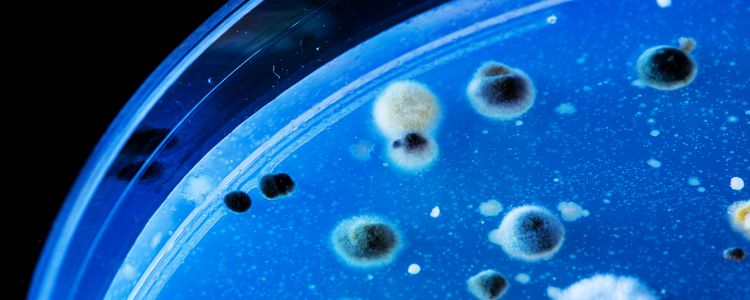
Нова «КРІСПР-пігулка» примушує бактерію знищити свою власну ДНК

Нова «КРІСПР-пігулка» примушує бактерію знищити свою власну ДНК
Цільові та їстівні
Оскільки стійкість до антибіотиків, продовжує зростати, вчені відчайдушно намагаються з'ясувати, як краще боротися з бактерією, як Clostridium незговірливий, що може викликати смертельні інфекції в лікарнях і будинках престарілих. C. незговірливий займають перше місце Центрів США по контролю і профілактиці захворювань (CDC) в якості верхньої лікарської стійкості загрози, відповідальної за приблизно 15 000 смертей на рік. Деякі засоби в даний час вивчаються для боротьби з пандемією, найостанніший виходячи з проекту, що фінансується Національним інститутом охорони здоров'я.
Пропоноване рішення використовує CRISPR, найбільш точна і ефективна в світі технологія редагування генів в даний час. Ян-Петер ван Pijkeren, харчової вчений з Університету Вісконсін-Медісон, створює пробіотичний коктейль, який пацієнти можуть проковтнути у вигляді рідини або таблетки.
Коктейль з бактерій включатиме бактеріофаг - вірус, який інфікує бактерію - здатний нести налаштовану, помилкове, CRISPR повідомлення для C. незговірливого. Це повідомлення викликало б C.difficile, щоб зробити летальні скорочень своєї власної ДНК.
Краще, ніж антибіотики
В даний час цей пробіотик все ще перебуває на ранніх стадіях, відповідно до ван Pijkeren, і ще не тестувався на тваринах. На щастя, подібні дослідження довели ефективність бактеріофагів доставляється CRISPR у вбивстві бактерій. Проте, дослідники досі є деякі проблеми.
«Недоліком антибіотиків вони кувалди, що виснажує і руйнує кишечник мікробного співтовариства,» сказав ван Pijkeren в Університеті Вісконсін-Медісон. «Ви хочете використовувати замість скальпеля для того, щоб конкретно викорінювати мікроб інтересу.»
CRISPR ідеально підходить для такого використання, оскільки такі препарати будуть дуже специфічними для користувача. Вони могли вбити один вид мікроба, залишаючи хороший бактеріальний недоторканими. У договорі, регулярні антибіотики вбивають як хороші і погані бактерії, що призводить до опору. Якщо виявилося успішним, CRISPR може стати, а не тільки в світі найбільш ефективним інструментом редагування генів, але і кращі технології, що вбивають бактерії доступні. Хоча це далеко, вона як і раніше дає надію тисячам.
«До тих пір, як ми вдома пацієнтів разом в лікарні або в будинку для літніх людей, і ми даємо багато з них антибіотики ми будемо мати проблеми з C. незговірливий,» говорить Герберт Дюпон, директор Центру інфекційних хвороб Техаський університет.
Посилання: Нове на MIT Technology Review, Університет Вісконсін-Медісон



